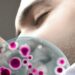
Studimi: 80 milionë baktere i transferoni njëri-tjetrit kur putheni

Prokuroria e Tiranës ka sekuestruar pasuritë e një personi, i cili ka ndërruar jetë në vitin 2022, pasi dyshohet se ato rrjedhin nga veprimtaria kriminale.
Sokrat Cari rezulton i dënuar për disa vepra penale si “Moskallëzim të krimit”, “Falsifikim të dokumențave” dhe “Prodhimi dhe shitje e lëndëve narkotike”.
Nga hetimet ka rezultuar se ky person dhe familjarët e tij nuk kanë pasur burime financiare për krijimin e pasurive që zotëronin deri në vitin 2005 dhe kanë një nivel të pajustifikuar ekonomik, çka sipas prokurorisë, vërteton se kjo pasuri është vënë si rezultat i veprimtarisë kriminale.
Organi i akuzës vlerësoi se kjo pasuri e luajtshme dyshohet se është fituar nga Sokrat Cari si rezultat i përfshirjes së tij në aktivitetin e prodhim dhe shitje narkotikësh.
Në vitin 2007, i ndjeri është shpallur fajtor për veprën penale ‘Falsifikim të dokumenteve’ ndërsa në 2011, u deklarua fajtor nga gjykata e Tiranës për Veprat Penale ‘Prodhimi dhe shitja e lëndëve narkotike’ dhe ‘Moskallëzim krimi’ për të cilin ka marrë edhe dënimin përkatës.
Pasuritë e sekuestruara:
- Pasuria e Paluajtshme Godinë banimi dhe shërbimi 3 kate me papafingo, zk 8250, sipërfaqje ndërtimi 156.2 m2, sipërfaqje totatale 388.6 m2, numri i kateve 4, Rruga “Besim Imami”, vila nr.34;
- Pasuria e Paluajtshme e llojit “Njësi”, Nr.5/605/ND-N15, vol 21, fq 159, ZK 8250, Sip 95.1m2, Rruga “Zhan D’Ark”, godina 10, kati përdhe, Tiranë;
- Automjeti Kamionçinë, blerë sipas Deklaratës Doganore 21.03.2005.

Discussion about this post